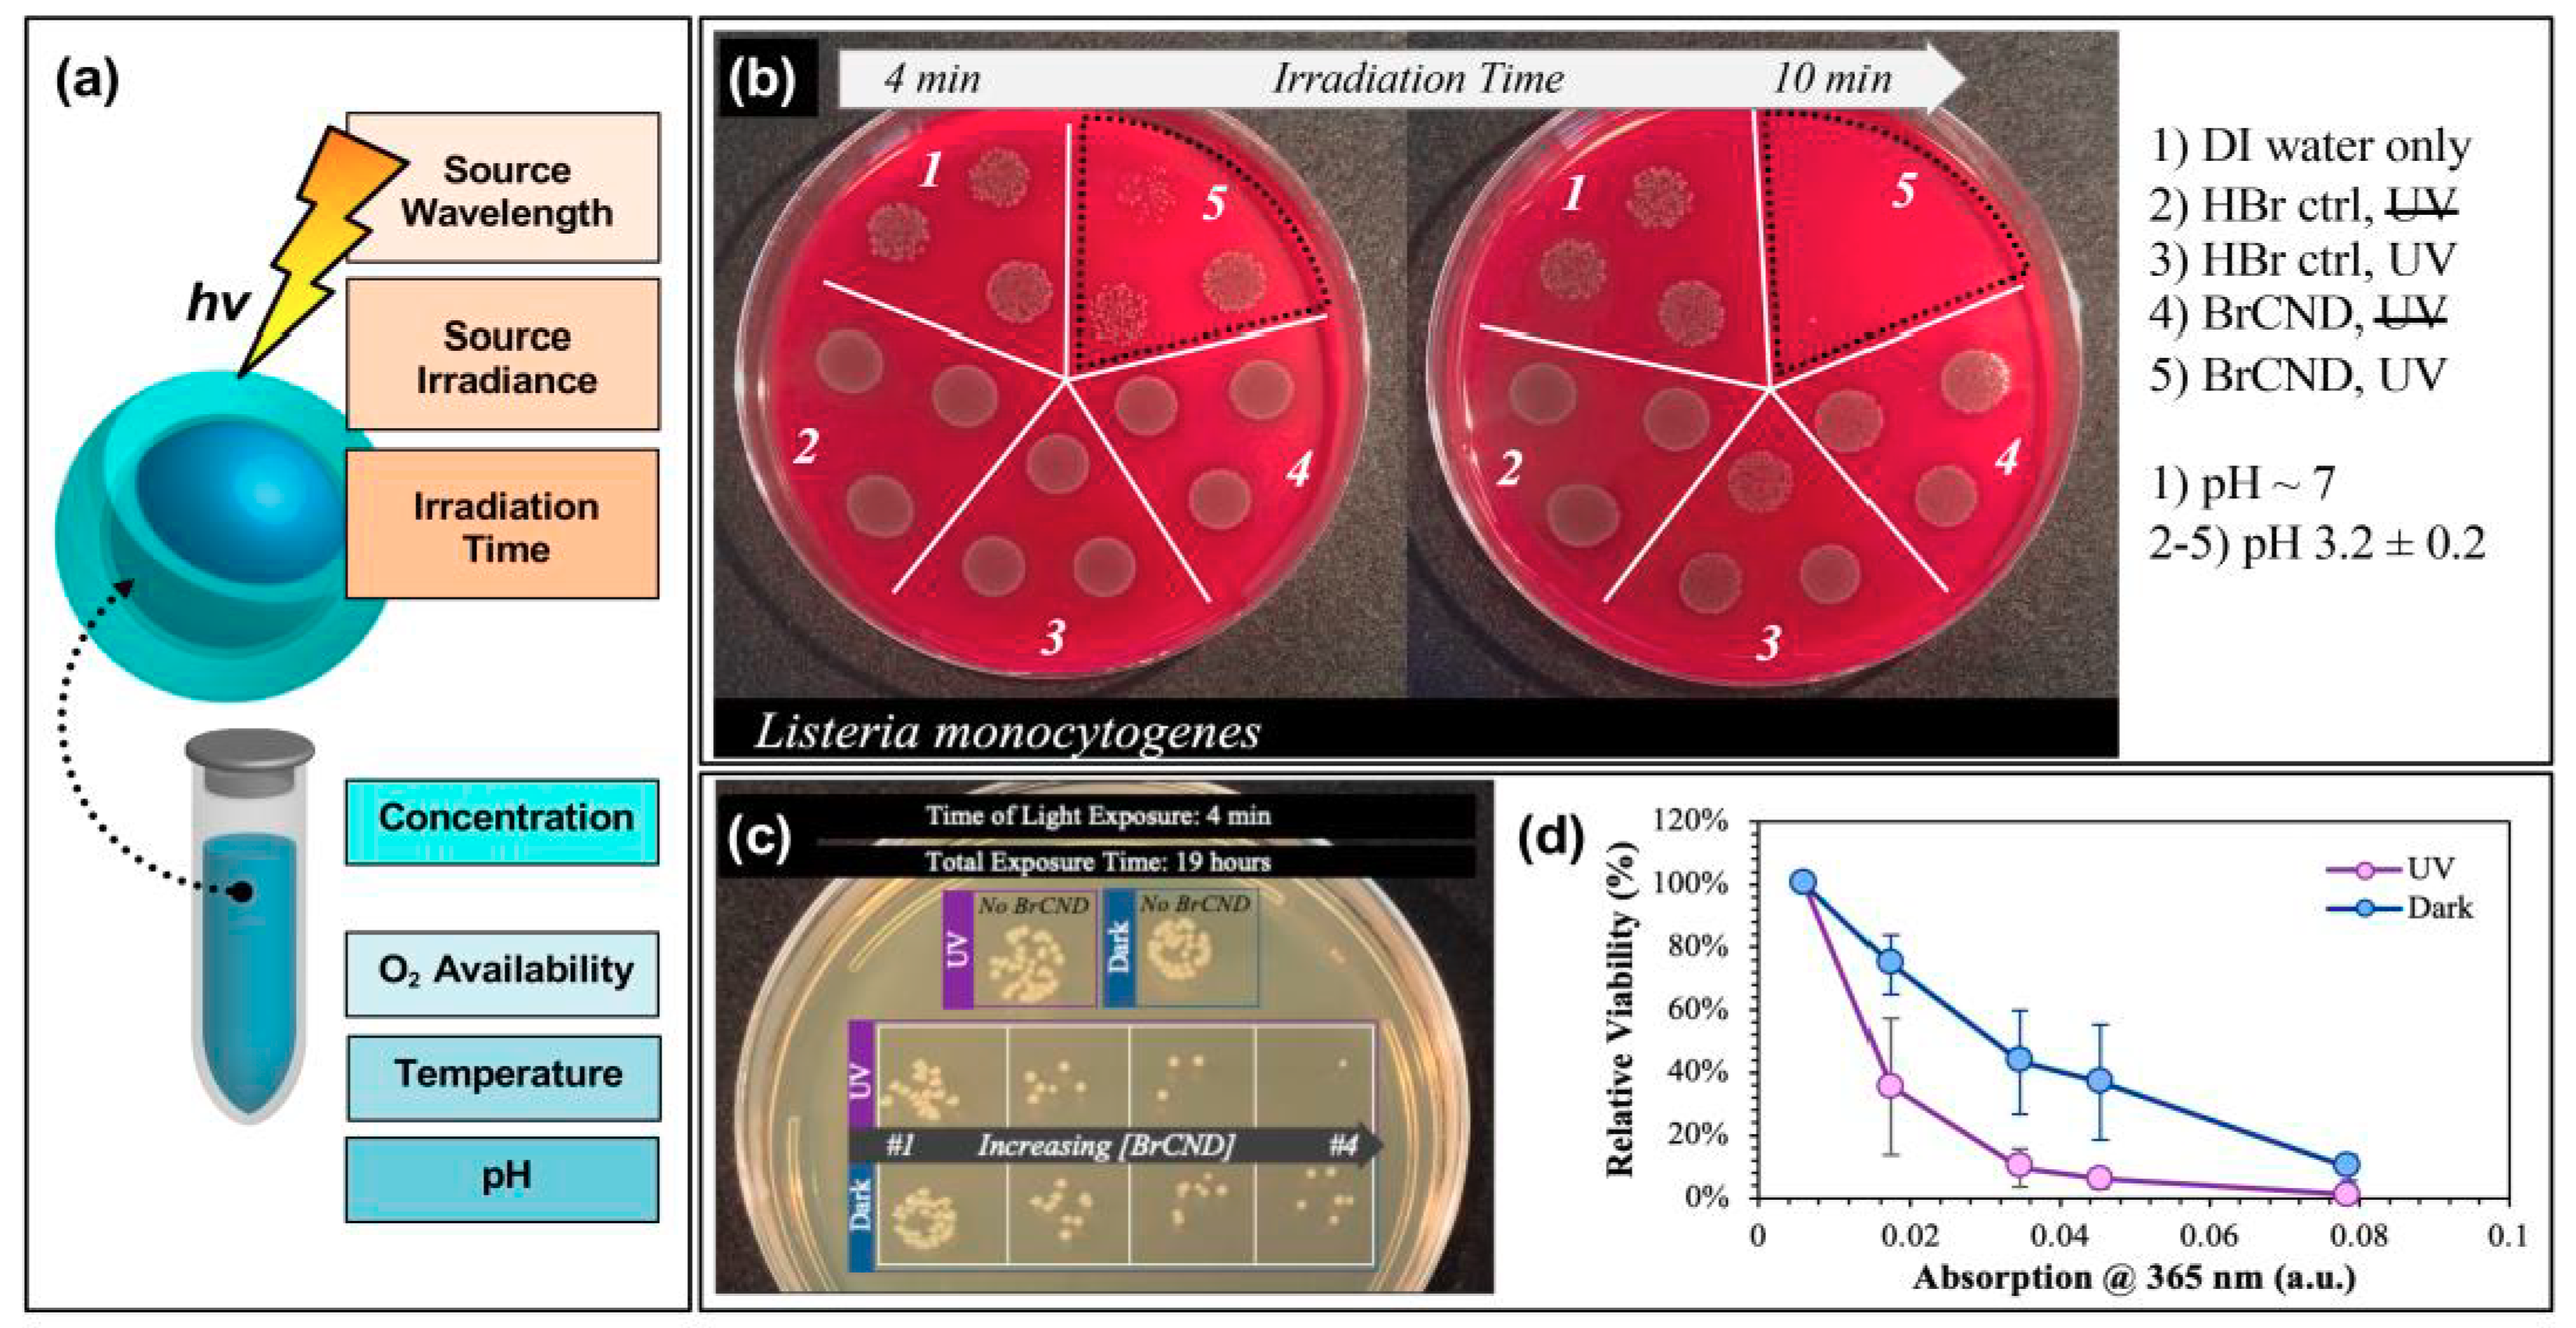
Materials 13 04004 g008

Carbon Nanodots in Photodynamic Antimicrobial Therapy: A Review
Abstract
1. Introduction: Photodynamic Antimicrobial Therapy and Carbon Nanodots
2. Characterization of Carbon Nanodots: An Overview of Key Spectroscopic/Physical Properties and Analysis Methods
3. Carbon Nanodots as Photodynamic Antimicrobial Agents
3.1. Generation and Detection of Reactive Oxygen Species from Carbon Nanodots
3.2. Photoinduced Antimicrobial Activity from Carbon Nanodots
3.3. Optimization of Antimicrobial Activity: Tuning of Luminescence Quantum Yields, Precursor Selection, Surface Charge, and Experimental Parameters
4. Carbon Nanodots in Hybrid Photodynamic Systems
4.1. Systems Containing Carbon Nanodots with Intrinsic Antimicrobial Character: Key Studies and Considerations
4.2. Systems Employing Carbon Nanodots to Improve Photophysical Properties: Fluorescence Resonance Energy Transfer and Upconversion Luminescence
4.3. Carbon Nanodots in Photodynamic Antimicrobial Materials
5. Practical Considerations
5.1. Cytotoxicity of Carbon Nanodots
5.2. Carbon Nanodot Definition and Characterization
6. Conclusions and Perspectives
Author Contributions
Funding
Acknowledgments
Conflicts of Interest
References
- Buroni, S.; Pollini, S.; Rossolini, G.M.; Perrin, E. Editorial: Evolution of Genetic Mechanisms of Antibiotic Resistance. Front. Genet. 2019, 10, 3. [Google Scholar] [CrossRef] [PubMed]
- Munita, J.M.; Arias, C.A. Mechanisms of Antibiotic Resistance. Microbiol. Spectr. 2016, 4, 24. [Google Scholar] [CrossRef] [PubMed]
- Mandal, S.; Prasad, S.R.; Mandal, D.; Das, P. Bovine Serum Albumin Amplified Reactive Oxygen Species Generation from Anthrarufin-Derived Carbon Dot and Concomitant Nanoassembly for Combination Antibiotic-Photodynamic Therapy Application. ACS Appl. Mater. Interfaces 2019, 11, 33273–33284. [Google Scholar] [CrossRef]
- Sib, E.; Voigt, A.M.; Wilbring, G.; Schreiber, C.; Faerber, H.A.; Skutlarek, D.; Parcina, M.; Mahn, R.; Wolf, D.; Brossart, P.; et al. Antibiotic resistant bacteria and resistance genes in biofilms in clinical wastewater networks. Int. J. Hyg. Environ. Health 2019, 222, 655–662. [Google Scholar] [CrossRef] [PubMed]
- Liu, Y.; Liu, X.; Xiao, Y.; Chen, F.; Xiao, F. A multifunctional nanoplatform based on mesoporous silica nanoparticles for imaging-guided chemo/photodynamic synergetic therapy. RSC Adv. 2017, 7, 31133–31141. [Google Scholar] [CrossRef]
- Russell, S.P.; Neary, C.; Abd Elwahab, S.; Powell, J.; O’Connell, N.; Power, L.; Tormey, S.; Merrigan, B.A.; Lowery, A.J. Breast infections—Microbiology and treatment in an era of antibiotic resistance. Surgery 2020, 18, 1–7. [Google Scholar] [CrossRef] [PubMed]
- Sattarahmady, N.; Rezaie-Yazdi, M.; Tondro, G.H.; Akbari, N. Bactericidal laser ablation of carbon dots: An in vitro study on wild-type and antibiotic-resistant Staphylococcus aureus. J. Photochem. Photobiol. B Biol. 2017, 166, 323–332. [Google Scholar] [CrossRef] [PubMed]
- Al-Shammery, D.; Michelogiannakis, D.; Ahmed, Z.U.; Ahmed, H.B.; Rossouw, P.E.; Romanos, G.E.; Javed, F. Scope of antimicrobial photodynamic therapy in Orthodontics and related research: A review. Photodiagn. Photodyn. Ther. 2019, 25, 456–459. [Google Scholar] [CrossRef]
- Agazzi, M.L.; Ballatore, M.B.; Durantini, A.M.; Durantini, E.N.; Tomé, A.C. BODIPYs in antitumoral and antimicrobial photodynamic therapy: An integrating review. J. Photochem. Photobiol. C Photochem. Rev. 2019, 40, 21–48. [Google Scholar] [CrossRef]
- Boltes Cecatto, R.; Siqueira de Magalhães, L.; Fernanda Setúbal Destro Rodrigues, M.; Pavani, C.; Lino-dos-Santos-Franco, A.; Teixeira Gomes, M.; Fátima Teixeira Silva, D. Methylene blue mediated antimicrobial photodynamic therapy in clinical human studies: The state of the art. Photodiagn. Photodyn. Ther. 2020, 31, 10. [Google Scholar] [CrossRef]
- Tim, M. Strategies to optimize photosensitizers for photodynamic inactivation of bacteria. J. Photochem. Photobiol. B Biol. 2015, 150, 2–10. [Google Scholar] [CrossRef] [PubMed]
- Zhang, J.; Liu, X.; Wang, X.; Mu, L.; Yuan, M.; Liu, B.; Shi, H. Carbon dots-decorated Na2W4O13 composite with WO3 for highly efficient photocatalytic antibacterial activity. J. Hazard. Mater. 2018, 359, 1–8. [Google Scholar] [CrossRef] [PubMed]
- Kanofsky, J.R. Chapter 5: Photosensitization. In Singlet Oxygen: Applications in Biosciences and Nanosciences; Nonell, S., Flors, C., Eds.; Royal Society of Chemistry: Cambridge, UK, 2016; Volume 1, pp. 93–103. [Google Scholar]
- Baptista, M.S.; Cadet, J.; Di Mascio, P.; Ghogare, A.A.; Greer, A.; Hamblin, M.R.; Lorente, C.; Nunez, S.C.; Ribeiro, M.S.; Thomas, A.H.; et al. Type I and Type II Photosensitized Oxidation Reactions: Guidelines and Mechanistic Pathways. Photochem. Photobiol. 2017, 93, 912–919. [Google Scholar] [CrossRef] [PubMed]
- Magaraggia, M.; Jori, G. Photodynamic Therapy in Treatment of Infectious Diseases: Basic Aspects and Mechanisms of Action. In Advances in Photodynamic Therapy: Basic, Translational, and Clinical; Mróz, P., Hamblin, M.R., Eds.; Artech House: Boston, MA, USA, 2008; pp. 337–357. [Google Scholar]
- Dong, X.; Bond, A.E.; Pan, N.; Coleman, M.; Tang, Y.; Sun, Y.-P.; Yang, L. Synergistic photoactivated antimicrobial effects of carbon dots combined with dye photosensitizers. Int. J. Nanomed. 2018, 13, 8025–8035. [Google Scholar] [CrossRef]
- Jijie, R.; Barras, A.; Bouckaert, J.; Dumitrascu, N.; Szunerits, S.; Boukherroub, R. Enhanced antibacterial activity of carbon dots functionalized with ampicillin combined with visible light triggered photodynamic effects. Colloids Surf. B Biointerfaces 2018, 170, 347–354. [Google Scholar] [CrossRef]
- Broekgaarden, M.; Weijer, R.; van Gulik, T.M.; Hamblin, M.R.; Heger, M. Tumor cell survival pathways activated by photodynamic therapy: A molecular basis for pharmacological inhibition strategies. Cancer Metastasis Rev. 2015, 34, 643–690. [Google Scholar] [CrossRef]
- Sidhu, J.S.; Pandiyan, T.; Kaur, N.; Singh, N. The Photochemical Degradation of Bacterial Cell Wall Using Penicillin-Based Carbon Dots: Weapons Against Multi-Drug Resistant (MDR) Strains. Chemistryselect 2017, 2, 9277–9283. [Google Scholar] [CrossRef]
- Nissan, I.; Kumar, V.B.; Porat, Z.; Makovec, D.; Shefi, O.; Gedanken, A. Sonochemically-fabricated Ga@C-dots@Ga nanoparticle-aided neural growth. J. Mater. Chem. B 2017, 5, 1371–1379. [Google Scholar] [CrossRef]
- Abu Rabe, D.I.; Al Awak, M.M.; Yang, F.; Okonjo, P.A.; Dong, X.; Teisl, L.R.; Wang, P.; Tang, Y.; Pan, N.; Sun, Y.-P.; et al. The dominant role of surface functionalization in carbon dots’ photo-activated antibacterial activity. Int. J. Nanomed. 2019, 14, 2655–2665. [Google Scholar] [CrossRef]
- Thakur, A.; Devi, P.; Saini, S.; Jain, R.; Sinha, R.K.; Kumar, P. Citrus limetta Organic Waste Recycled Carbon Nanolights: Photoelectro Catalytic, Sensing, and Biomedical Applications. ACS Sustain. Chem. Eng. 2019, 7, 502–512. [Google Scholar] [CrossRef]
- Prieto-Montero, R.; Prieto-Castañeda, A.; Sola-Llano, R.; Agarrabeitia, A.R.; García-Fresnadillo, D.; López-Arbeloa, I.; Villanueva, A.; Ortiz, M.J.; de la Moya, S.; Martínez-Martínez, V. Exploring BODIPY Derivatives as Singlet Oxygen Photosensitizers for PDT. Photochem. Photobiol. 2020, 96, 458–477. [Google Scholar] [CrossRef] [PubMed]
- Al Awak, M.M.; Wang, P.; Wang, S.; Tang, Y.; Sun, Y.-P.; Yang, L. Correlation of carbon dots’ light-activated antimicrobial activities and fluorescence quantum yield. RSC. Adv. 2017, 7, 30177–30184. [Google Scholar] [CrossRef] [PubMed]
- Zhao, F.; Gu, W.; Zhou, J.; Liu, Q.; Chong, Y. Solar-excited graphene quantum dots for bacterial inactivation via generation of reactive oxygen species. J. Environ. Sci. Health Part C 2019, 37, 67–80. [Google Scholar] [CrossRef] [PubMed]
- Meziani, M.J.; Dong, X.L.; Zhu, L.; Jones, L.P.; LeCroy, G.E.; Yang, F.; Wang, S.Y.; Wang, P.; Zhao, Y.P.; Yang, L.J.; et al. Visible-Light-Activated Bactericidal Functions of Carbon “Quantum” Dots. ACS Appl. Mater. Interfaces 2016, 8, 10761–10766. [Google Scholar] [CrossRef] [PubMed]
- Hazarika, D.; Saikia, D.; Gupta, K.; Mandal, M.; Karak, N. Photoluminescence, Self cleaning and Photocatalytic Behavior of Waterborne Hyperbranched Polyester/Carbon dot@TiO2 Nanocomposite. Chemistryselect 2018, 3, 6126–6135. [Google Scholar] [CrossRef]
- Gao, Z.; Zhao, C.-X.; Li, Y.-Y.; Yang, Y.-L. Beer yeast-derived fluorescent carbon dots for photoinduced bactericidal functions and multicolor imaging of bacteria. Appl. Microbiol. Biotechnol. 2019, 103, 4585–4593. [Google Scholar] [CrossRef]
- Lin, F.M.; Bao, Y.W.; Wu, F.G. Carbon Dots for Sensing and Killing Microorganisms. C-J. Carbon Res. 2019, 5, 21. [Google Scholar] [CrossRef]
- Dong, X.; Liang, W.; Meziani, M.J.; Sun, Y.-P.; Yang, L. Carbon Dots as Potent Antimicrobial Agents. Theranostics 2020, 10, 671–686. [Google Scholar] [CrossRef]
- Anand, A.; Unnikrishnan, B.; Wei, S.-C.; Chou, C.P.; Zhang, L.-Z.; Huang, C.-C. Graphene oxide and carbon dots as broad-spectrum antimicrobial agents—a minireview. Nanoscale Horiz. 2019, 4, 117–137. [Google Scholar] [CrossRef]
- Al-Jumaili, A.; Alancherry, S.; Bazaka, K.; Jacob, M.V. Review on the Antimicrobial Properties of Carbon Nanostructures. Materials 2017, 10, 1066. [Google Scholar] [CrossRef]
- Hamblin, M.R.; Sperandio, F.F.; Gupta, A. Photodynamic Therapy Mediated by Fullerenes and Their Derivatives; Momentum Press: New York, NY, USA, 2013. [Google Scholar]
- Jovanović, S.; Marković, Z.; Todorović Marković, B. Carbon Based Nanomaterials as Agents for Photodynamic Therapy In Photodynamic Therapy (PDT): Principles, Mechanisms and Applications; Fitzgerald, F., Ed.; Nova Science Publishers, Inc.: New York, NY, USA, 2017; pp. 45–108. [Google Scholar]
- Qi-Long, Y.; Gozin, M.; Feng-Qi, Z.; Cohen, A.; Si-Ping, P. Highly energetic compositions based on functionalized carbon nanomaterials. Nanoscale 2016, 8, 4799–4851. [Google Scholar] [CrossRef]
- Stankovic, N.K.; Bodik, M.; Siffalovic, P.; Kotlar, M.; Micusik, M.; Spitalsky, Z.; Danko, M.; Milivojevic, D.D.; Kleinova, A.; Kubat, P.; et al. Antibacterial and Antibiofouling Properties of Light Triggered Fluorescent Hydrophobic Carbon Quantum Dots Langmuir-Blodgett Thin Films. ACS Sustain. Chem. Eng. 2018, 6, 4154–4163. [Google Scholar] [CrossRef]
- Jiang, L.; Ding, H.; Xu, M.; Hu, X.; Li, S.; Zhang, M.; Zhang, Q.; Wang, Q.; Lu, S.; Tian, Y.; et al. UV-Vis-NIR Full-Range Responsive Carbon Dots with Large Multiphoton Absorption Cross Sections and Deep-Red Fluorescence at Nucleoli and In Vivo. Small 2020, 16, 9. [Google Scholar] [CrossRef] [PubMed]
- Guo, X.-L.; Ding, Z.-Y.; Deng, S.-M.; Wen, C.-C.; Shen, X.-C.; Jiang, B.-P.; Liang, H. A novel strategy of transition-metal doping to engineer absorption of carbon dots for near-infrared photothermal/photodynamic therapies. Carbon 2018, 134, 519–530. [Google Scholar] [CrossRef]
- Ortega-Liebana, M.C.; Encabo-Berzosa, M.M.; Ruedas-Rama, M.J.; Hueso, J.L. Nitrogen-Induced Transformation of Vitamin C into Multifunctional Up-converting Carbon Nanodots in the Visible-NIR Range. Chem. Eur. J. 2017, 23, 3067–3073. [Google Scholar] [CrossRef]
- Zhang, J.; An, X.; Li, X.; Liao, X.; Nie, Y.; Fan, Z. Enhanced antibacterial properties of the bracket under natural light via decoration with ZnO/carbon quantum dots composite coating. Chem. Phys. Lett. 2018, 706, 702–707. [Google Scholar] [CrossRef]
- Shoujun, Z.; Yubin, S.; Xiaohuan, Z.; Jieren, S.; Junhu, Z.; Bai, Y. The photoluminescence mechanism in carbon dots (graphene quantum dots, carbon nanodots, and polymer dots): Current state and future perspective. Nano Res. 2015, 8, 355–381. [Google Scholar] [CrossRef]
- Ding, H.; Li, X.-H.; Chen, X.-B.; Wei, J.-S.; Li, X.-B.; Xiong, H.-M. Surface states of carbon dots and their influences on luminescence. J. Appl. Phys. 2020, 127, 1–21. [Google Scholar] [CrossRef]
- Lian, X.; Yue, W.; Yi, H.; Teckneng, W.; Handong, S. Self-trapped exciton emission from carbon dots investigated by polarization anisotropy of photoluminescence and photoexcitation. Nanoscale 2017, 9, 12637–12646. [Google Scholar] [CrossRef]
- Schmitz, R. Synthesis, Characterization, and Plasmonic Enhancement of Fluorescent Carbon Nanodots. Ph.D. Thesis, University of Maryland Baltimore County, Baltimore, MD, USA, 2016. [Google Scholar]
- Roy, P.; Chen, P.-C.; Periasamy, A.P.; Chen, Y.-N.; Chang, H.-T. Photoluminescent carbon nanodots: Synthesis, physicochemical properties and analytical applications. Mater. Today 2015, 18, 447–458. [Google Scholar] [CrossRef]
- Knoblauch, R.; Bui, B.; Raza, A.; Geddes, C.D. Heavy carbon nanodots: A new phosphorescent carbon nanostructure. Phys. Chem. Chem. Phys. 2018, 20, 15518–15527. [Google Scholar] [CrossRef]
- Schmitz, R.D.; Knoblauch, R.; Ra, E.; Geddes, C.D. Alpha-fluorescence (αS1) from thermally stable carbon nanodots. Chem. Phys. Lett. 2019, 721, 123–128. [Google Scholar] [CrossRef]
- Devi, P.; Thakur, A.; Bhardwaj, S.K.; Saini, S.; Rajput, P.; Kumar, P. Metal ion sensing and light activated antimicrobial activity of aloe-vera derived carbon dots. J. Mater. Sci. Mater. Electron. 2018, 29, 17254–17261. [Google Scholar] [CrossRef]
- Kavitha, T.; Kumar, S. Turning date palm fronds into biocompatible mesoporous fluorescent carbon dots. Sci. Rep. 2018, 8, 16269. [Google Scholar] [CrossRef] [PubMed]
- Verma, A.; Arshad, F.; Ahmad, K.; Goswami, U.; Samanta, S.K.; Sahoo, A.K.; Sk, M.P. Role of surface charge in enhancing antibacterial activity of fluorescent carbon dots. Nanotechnology 2020, 31, 095101–095109. [Google Scholar] [CrossRef]
- Gao, Z.; Yang, D.Z.; Wan, Y.; Yang, Y.L. One-step synthesis of carbon dots for selective bacterial inactivation and bacterial differentiation. Anal. Bioanal. Chem. 2020, 412, 871–880. [Google Scholar] [CrossRef]
- Naqvi, S.T.R.; Rasheed, T.; Majeed, S.; Rani, Z.; Nawaz, R.; Ashiq, M.N. Development of nitrogen doped carbon dots modified CuCo alloy nanoparticles for potential electrocatalytic water splitting. J. Mol. Liq. 2020, 309, 9. [Google Scholar] [CrossRef]
- Essner, J.B.; Baker, G.A. The emerging roles of carbon dots in solar photovoltaics: A critical review. Environ. Sci. Nano 2017, 4, 1216–1263. [Google Scholar] [CrossRef]
- Sai, L.; Ziwei, W.; Yijun, Z.; Yunyun, H.; Rongrong, Y.; Weidong, X.; Yongqiang, Z. Easy synthesis of silver nanoparticles-orange emissive carbon dots hybrids exhibiting enhanced fluorescence for white light emitting diodes. J. Alloy. Compd. 2017, 700, 75–82. [Google Scholar] [CrossRef]
- Zhang, J.; Lu, X.; Tang, D.; Wu, S.; Hou, X.; Liu, J.; Wu, P. Phosphorescent Carbon Dots for Highly Efficient Oxygen Photosensitization and as Photo-oxidative Nanozymes. ACS Appl. Mater. Interfaces 2018, 10, 40808–40814. [Google Scholar] [CrossRef]
- Knoblauch, R.; Harvey, A.; Ra, E.; Greenberg, K.M.; Lau, J.; Hawkins, E.; Geddes, C.D. Antimicrobial Carbon Nanodots: Photodynamic Inactivation and Dark Toxicity Effects on Bacteria by Brominated Carbon Nanodots. Nanoscale 2020. submitted. [Google Scholar]
- Du, F.F.; Shuang, S.M.; Guo, Z.H.; Gong, X.J.; Dong, C.; Xian, M.; Yang, Z.H. Rapid synthesis of multifunctional carbon nanodots as effective antioxidants, antibacterial agents, and quercetin nanoprobes. Talanta 2020, 206, 120243–120248. [Google Scholar] [CrossRef] [PubMed]
- Shahshahanipour, M.; Rezaei, B.; Ensafi, A.A.; Etemadifar, Z. An ancient plant for the synthesis of a novel carbon dot and its applications as an antibacterial agent and probe for sensing of an anti-cancer drug. Mater. Sci. Eng. C Mater. Biol. Appl. 2019, 98, 826–833. [Google Scholar] [CrossRef] [PubMed]
- Kumari, S.; Prasad, S.R.; Mandal, D.; Das, P. Carbon dot-DNA-protoporphyrin hybrid hydrogel for sustained photoinduced antimicrobial activity. J. Colloid Interface Sci. 2019, 553, 228–238. [Google Scholar] [CrossRef]
- Knoblauch, R.; Harvey, A.; Geddes, C.D. Metal-enhanced photosensitization of singlet oxygen (ME1O2) from brominated carbon nanodots on silver nanoparticle substrates. Plasmonics 2020. submitted. [Google Scholar]
- Li, H.; Huang, J.; Song, Y.; Zhang, M.; Wang, H.; Lu, F.; Huang, H.; Liu, Y.; Dai, X.; Gu, Z.; et al. Degradable Carbon Dots with Broad-Spectrum Antibacterial Activity. ACS Appl. Mater. Interfaces 2018, 10, 26936–26946. [Google Scholar] [CrossRef]
- Ju, B.; Nie, H.; Zhang, X.G.; Chen, Q.N.; Guo, X.W.; Xing, Z.; Li, M.J.; Zhang, S.X.A. Inorganic Salt Incorporated Solvothermal Synthesis of Multicolor Carbon Dots, Emission Mechanism, and Antibacterial Study. ACS Appl. Nano Mater. 2018, 1, 6131–6138. [Google Scholar] [CrossRef]
- Ran, H.H.; Cheng, X.T.; Bao, Y.W.; Hua, X.W.; Gao, G.; Zhang, X.D.; Jiang, Y.W.; Zhu, Y.X.; Wu, F.G. Multifunctional quaternized carbon dots with enhanced biofilm penetration and eradication efficiencies. J. Mater. Chem. B 2019, 7, 5104–5114. [Google Scholar] [CrossRef]
- Zhu, C.; Li, H.; Wang, H.B.; Yao, B.W.; Huang, H.; Liu, Y.; Kang, Z.H. Negatively Charged Carbon Nanodots with Bacteria Resistance Ability for High-Performance Antibiofilm Formation and Anticorrosion Coating Design. Small 2019, 15. [Google Scholar] [CrossRef]
- Jhonsi, M.A.; Ananth, D.A.; Nambirajan, G.; Sivasudha, T.; Yamini, R.; Bera, S.; Kathiravan, A. Antimicrobial activity, cytotoxicity and DNA binding studies of carbon dots. Spectrochim. Acta Part A Mol. Biomol. Spectrosc. 2018, 196, 295–302. [Google Scholar] [CrossRef]
- Chatzimitakos, T.G.; Kasouni, A.I.; Troganis, A.N.; Stalikas, C.D. Exploring the antibacterial potential and unraveling the mechanism of action of non-doped and heteroatom-doped carbon nanodots. J. Nanoparticle Res. 2020, 22. [Google Scholar] [CrossRef]
- Yang, J.; Zhang, X.; Ma, Y.-H.; Gao, G.; Chen, X.; Jia, H.-R.; Li, Y.-H.; Chen, Z.; Wu, F.-G. Carbon Dot-Based Platform for Simultaneous Bacterial Distinguishment and Antibacterial Applications. ACS Appl. Mater. Interfaces 2016, 8, 32170–32181. [Google Scholar] [CrossRef] [PubMed]
- Yang, J.J.; Gao, G.; Zhang, X.D.; Ma, Y.H.; Chen, X.K.; Wu, F.G. One-step synthesis of carbon dots with bacterial contact-enhanced fluorescence emission: Fast Gram-type Identification and selective Gram-positive bacterial inactivation. Carbon 2019, 146, 827–839. [Google Scholar] [CrossRef]
- Tao, S.; Lu, S.; Geng, Y.; Zhu, S.; Redfern, S.A.T.; Song, Y.; Feng, T.; Xu, W.; Yang, B. Design of Metal-Free Polymer Carbon Dots: A New Class of Room-Temperature Phosphorescent Materials. Angew. Chem. Int. Ed. 2018, 130, 2417–2422. [Google Scholar] [CrossRef]
- Turro, N.J. Modern Molecular Photochemistry; University Science Books: Mill Valley, CA, USA, 1991. [Google Scholar]
- Liu, J.J.; Lu, S.Y.; Tang, Q.L.; Zhang, K.; Yu, W.X.; Sun, H.C.; Yang, B. One-step hydrothermal synthesis of photoluminescent carbon nanodots with selective antibacterial activity against Porphyromonas gingivalis. Nanoscale 2017, 9, 7135–7142. [Google Scholar] [CrossRef] [PubMed]
- Hou, P.; Yang, T.; Liu, H.; Li, Y.F.; Huang, C.Z. An active structure preservation method for developing functional graphitic carbon dots as an effective antibacterial agent and a sensitive pH and Al(III) nanosensor. Nanoscale 2017, 9, 17334–17341. [Google Scholar] [CrossRef]
- Dong, X.; Al Awak, M.; Tomlinson, N.; Tang, Y.; Sun, Y.-P.; Yang, L. Antibacterial effects of carbon dots in combination with other antimicrobial reagents. PLoS ONE 2017, 12, e0185324. [Google Scholar] [CrossRef]
- Pan, J.; Sheng, Y.; Zhang, J.; Wei, J.; Huang, P.; Zhang, X.; Feng, B. Preparation of carbon quantum dots/TiO2 nanotubes composites and their visible light catalytic applications. J. Mater. Chem. A 2014, 2, 18082–18086. [Google Scholar] [CrossRef]
- Knoblauch, R.; Geddes, C.D. Reviews of Advances in Metal-Enhanced Fluorescence. In Reviews in Plasmonics 2017; Geddes, C.D., Ed.; Springer International Publishing: Cham, Switzerland, 2019; pp. 253–283. [Google Scholar]
- Schmitz, R.D.; Karolin, J.O.; Geddes, C.D. Plasmonic enhancement of intrinsic carbon nanodot emission. Chem. Phys. Lett. 2015, 622, 124–127. [Google Scholar] [CrossRef]
- Knoblauch, R.; Ra, E.; Geddes, C.D. Heavy carbon nanodots 2: Plasmon amplification in Quanta Plate™ wells and the correlation with the synchronous scattering spectrum. Phys. Chem. Chem. Phys. 2019, 21, 1254–1259. [Google Scholar] [CrossRef]
- Geddes, C.D. Metal-enhanced fluorescence based excitation volumetric effect of plasmon-enhanced singlet oxygen and super oxide generation. Phys. Chem. Chem. Phys. 2013, 15, 15740–15745. [Google Scholar]
- Zhang, Y.; Aslan, K.; Previte, M.J.R.; Geddes, C.D. Plasmonic Engineering of Singlet Oxygen Generation. Proc. Natl. Acad. Sci. USA 2008, 1798–1802. [Google Scholar] [CrossRef] [PubMed]
- Zhang, Y.; Aslan, K.; Previte, M.J.R.; Geddes, C.D. Metal-enhanced superoxide generation: A consequence of plasmon-enhanced triplet yields. Appl. Phys. Lett. 2007, 91. [Google Scholar] [CrossRef]
- Duarah, R.; Singh, Y.P.; Gupta, P.; Mandal, B.B.; Karak, N. High performance bio-based hyperbranched polyurethane/carbon dot-silver nanocomposite: A rapid self-expandable stent. Biofabrication 2016, 8, 045013–045022. [Google Scholar] [CrossRef]
- Wang, K.J.; Ji, Q.J.; Li, H.X.; Guan, F.; Zhang, D.Y.; Feng, H.X.; Fan, H.Y. Synthesis and antibacterial activity of silver@carbon nanocomposites. J. Inorg. Biochem. 2017, 166, 64–67. [Google Scholar] [CrossRef]
- Roh, S.G.; Robby, A.I.; Pham Thi My, P.; In, I.; Park, S.Y. Photoluminescence-tunable fluorescent carbon dots-deposited silver nanoparticle for detection and killing of bacteria. Mater. Sci. Eng. C Mater. Biol. Appl. 2019, 97, 613–623. [Google Scholar] [CrossRef]
- Fang, H.-Y.; Huang, W.-M.; Chen, D.-H. One-step synthesis of positively charged bifunctional carbon dot/silver composite nanoparticles for killing and fluorescence imaging of Gram-negative bacteria. Nanotechnology 2019, 30, 365603–365608. [Google Scholar] [CrossRef]
- Jin, J.-C.; Xu, Z.-Q.; Dong, P.; Lai, L.; Lan, J.-Y.; Jiang, F.-L.; Liu, Y. One-step synthesis of silver nanoparticles using carbon dots as reducing and stabilizing agents and their antibacterial mechanisms. Carbon 2015, 94, 129–141. [Google Scholar] [CrossRef]
- Hu, M.; Gu, X.Y.; Hu, Y.; Deng, Y.H.; Wang, C.Y. PVA/Carbon Dot Nanocomposite Hydrogels for Simple Introduction of Ag Nanoparticles with Enhanced Antibacterial Activity. Macromol. Mater. Eng. 2016, 301, 1352–1362. [Google Scholar] [CrossRef]
- Han, S.; Zhang, H.; Kang, L.W.; Li, X.L.; Zhang, C.; Dong, Y.J.; Qin, S.J. A Convenient Ultraviolet Irradiation Technique for Synthesis of Antibacterial Ag-Pal Nanocomposite. Nanoscale Res. Lett. 2016, 11, 8. [Google Scholar] [CrossRef]
- Xu, Z.Q.; He, H.; Zhang, S.Y.; Wang, B.B.; Jin, J.C.; Li, C.; Chen, X.Q.; Jiang, B.B.; Liu, Y. Mechanistic studies on the antibacterial behavior of Ag nanoparticles decorated with carbon dots having different oxidation degrees. Environ. Sci. Nano 2019, 6, 1168–1179. [Google Scholar] [CrossRef]
- Omidi, M.; Yadegari, A.; Tayebi, L. Wound dressing application of pH-sensitive carbon dots/chitosan hydrogel. RSC Adv. 2017, 7, 10638–10649. [Google Scholar] [CrossRef]
- Thakur, M.; Pandey, S.; Mewada, A.; Patil, V.; Khade, M.; Goshi, E.; Sharon, M. Antibiotic Conjugated Fluorescent Carbon Dots as a Theranostic Agent for Controlled Drug Release, Bioimaging, and Enhanced Antimicrobial Activity. J. Drug Deliv. 2014, 2014, 282193–282199. [Google Scholar] [CrossRef] [PubMed]
- Cheng, K.; Qi, R.; Lan, S.; Wang, H.; Zheng, X.; Liu, C.; Jia, D.; Cao, L.; Wang, D. Tunable excitation-dependent-fluorescence of carbon dots: Fingerprint curves for super anti-counterfeiting. Dye. Pigment. 2020, 174, 10. [Google Scholar] [CrossRef]
- Wang, J.; Qiu, J. A review of carbon dots in biological applications. J. Mater. Sci. 2016, 51, 4728–4738. [Google Scholar] [CrossRef]
- Tao, H.; Yang, K.; Ma, Z.; Wan, J.; Zhang, Y.; Kang, Z.; Liu, Z. In Vivo NIR Fluorescence Imaging, Biodistribution, and Toxicology of Photoluminescent Carbon Dots Produced from Carbon Nanotubes and Graphite. Small 2012, 8, 281–290. [Google Scholar] [CrossRef]
- Kumar, R.; Mpip, A.K.B.; Koynov, K.; Ohulchanskyy, T.; Li, Q.; Ohulchanskyy, T.Y.; Bonoiu, A.; Prasad, P.N.; Liu, R.; Wu, D.; et al. Photoluminescent Carbon Dots as Biocompatible Nanoprobes for Targeting Cancer Cells in Vitro. J. Phys. Chem. C 2010, 114, 12062–12068. [Google Scholar]
- Usman, M.; Zaheer, Y.; Younis, M.R.; Demirdogen, R.E.; Hussain, S.Z.; Sarwar, Y.; Rehman, M.; Khan, W.S.; Ihsan, A. The effect of surface charge on cellular uptake and inflammatory behavior of carbon dots. Colloid Interface Sci. Commun. 2020, 35, 8. [Google Scholar] [CrossRef]
- Lesani, P.; Ardekani, S.M.; Dehghani, A.; Hassan, M.; Gomes, V.G. Excitation-independent carbon dot probes for exogenous and endogenous Fe3+ sensing in living cells: Fluorescence lifetime and sensing mechanism. Sens. Actuators B Chem. 2019, 285, 145–155. [Google Scholar] [CrossRef]
- Gan, Z.; Xu, H.; Hao, Y. Mechanism for excitation-dependent photoluminescence from graphene quantum dots and other graphene oxide derivates: Consensus, debates and challenges. Nanoscale 2016, 8, 7794–7807. [Google Scholar] [CrossRef]

| This Work | Parameters | Ref. Details | |||||||||
|---|---|---|---|---|---|---|---|---|---|---|---|
| Figure | Panel | CND Label a | Diameter | Charge b | [CND] | Source | Power | Distance | Time | Ref. | Figure |
| 3 | b | CDs/Na2W4O13/WO3 photocatalyst | ~6 nm | n.d. | 1 mg/mL photocatalyst | visible light (>400 nm) | 300 W Xe lamp | n.d. | 0–100 min | [12] | 7 |
| 3 | c | brominated CND | ~5 nm | negative | n.d. | 365 nm | 100 W lamp | ~20 cm | 4 min | [56] | 3a |
| 3 | d | (T1) C-dots | ~1.6 nm | n.d. | n.d. | 365 nm | 3V, 3W LED | n.d. | RT | [55] | 2d |
| 3 | e | LB hydrophobic CQDs thin film | 5 nm/~1 nm (height) | n.d. | n.d. | 470 nm | 15 W | 50 cm * | 2 h | [36] | 4c |
| 4 | a (top) | brominated CND | ~5 nm | negative | n.d. | 365 nm | 3.0 ± 0.1 mW | ~15 cm | 5 min | [56] | 6a |
| 4 | a (middle) | brominated CND | ~5 nm | negative | n.d. | N/A | N/A | N/A | N/A | [56] | 6b |
| 4 | a (bottom) | brominated CND | ~5 nm | negative | n.d. | 365 nm | 3.0 ± 0.1 mW | ~15 cm | 5 min | [56] | 6c |
| 4 | b | brominated CND | ~5 nm | negative | n.d. | 365 nm | 3.0 ±. 0.1 mW | ~15 cm | 5 min | [56] | 6d |
| 4 | c | EDA-Cdots | ~5 nm | positive † [21] | n.d. | visible light | 12V 36W bulb | n.d. | 0-8 h | [26] | 5 |
| 5 | a | EDA-Cdots | 4–5 nm | positive † [21] | 5 μg/mL | white light bulb | 36W | 10 cm | 1 h | [16] | 4a,b |
| 5 | b (left) | Cdots (from date palm fronds) | ~50 nm | neutral | 70 μg/mL | room light | 50 W LED | 8 ft ceiling | 0 h | [49] | 8b |
| 5 | b (right) | Cdots (from date palm fronds) | ~50 nm | neutral | 70 μg/mL | room light | 50 W LED | 8 ft ceiling | 10 h | [49] | 8c |
| 6 | b | EDA-Cdots | < 5 nm | positive † [21] | 15.8 μg/mL | visible (“lab”) light | 12V 36W LED | 10 cm | 1, 3 h | [24] | 3a |
| 6 | c (left) | (T1) C-dots in PVA matrix | ~1.6 nm | n.d. | 0.1 μg/mL | UV * | n.d. | n.d. | N/A | [55] | 3a |
| 6 | c (right) | (T1) C-dots | ~1.6 nm | n.d. | n.d. | 365 nm * | 3V, 3W LED * | n.d. | Seconds * | [55] | 3c |
| 6 | d (bottom) | “water dots”/”Br dots” | <10 nm | n.d. | n.d. | 300 nm | n.d. | N/A | N/A | [46] | 2b |
| 6 | d (top) | “water dots”/”Br dots” | <10 nm | n.d. | n.d. | 300 nm | n.d. | N/A | N/A | [46] | 2a |
| 6 | e | brominated CND | ~5 nm | negative | n.d. | 365 nm | 3.0 ± 0.2 mW | ~15 cm | 4 min | [56] | 7b |
| 7 | b | EDA-Cdots/EPA-Cdots | 4–5 nm | EDA-(positive)/EPA-(neutral) | 0.1–0.2 mg/mL | visible light (400–800 nm) | 36W 12V bulb | 10 cm | 1 h | [21] | 2 |
| 8 | b | brominated CND | ~5 nm | negative | n.d. | 365 nm | ~3 mW | ~15 cm | 4, 10 min | [56] | 4b |
| 8 | c/d | brominated CND | ~5 nm | negative | n.d. | 365 nm | 3.0 ± 0.2 mW | ~15 cm | 4 min | [56] | 8a,b |
| This Work | Parameters | Ref. Details | |||||||||
|---|---|---|---|---|---|---|---|---|---|---|---|
| Figure | Panel | CND Label a | Diameter | Charge b | [CND] | Source | Power | Distance | Time | Ref. | Figure |
| 9 | a | EDA-Cdots | 4–5 nm | positive † [21] | 5 μg/mL | white light bulb | 36 W | 10 cm | 1 h | [16] | 1c |
| 9 | b | EDA-Cdots | 4–5 nm | positive † [21] | 0–64 μg/mL | visible light | 12 V 36 W bulb | 10 cm | 1 h | [73] | 3 |
| 9 | c | brominated CND | n.d. | n.d. | n.d. | 365 nm | 100 W lamp | ~20 cm | 4 min | [60] | 5b |
| 10 | a | CDs/CDs-Penicillin/PCDs | 4 nm/47 nm/5 nm | n.d. | 30 μg/mL | daylight | n.d. | n.d. | 0–9 h | [19] | 3c |
| 10 | b | BSA-CD NP/BSA-CD-Cipro NP | 60–70 nm /~110–120 nm | -21.3 mV | 1.47 μg/mL | Tungsten bulb (300–900 nm) | 100 W | 30 cm | 1 h | [3] | 6c |
| 11 | a/b | Cdots (from date palm fronds) with H2O2 | ~50 nm | neutral | 9 μg/mL | sunlight | n.d. | n.d. | 0–3 h | [49] | 7a/b |
| 11 | c | CD/BSA-CD/BSA-CD NP | ~5/8.5/60–70 nm | n.d./n.d. /−21.3 mV | n.d. | Tungsten bulb (300–900 nm) | 100 W | 30 cm * | 0–120 min | [3] | 5c |
| 11 | d | BSA-CD-Cipro NP | ~110–120 nm | −21.3 mV | n.d. | N/A | N/A | N/A | 0–60 h | [3] | 5d |
| 12 | b | CD-DNA | ~5 nm (pre-DNA) | negative * | n.d. | N/A | N/A | N/A | N/A | [59] | 1b |
| 12 | c | CD-DNA | ~5 nm (pre-DNA) | negative * | n.d. | 410 nm | N/A | N/A | N/A | [59] | 1c |
| 12 | e | ZnO/CQDs/Bracket | ~7 nm † [74] | n.d. | 1.5 mg/mL (pre-coating) | 550–850 nm | N/A | N/A | N/A | [40] | 6b |
| 12 | f | ZnO/CQDs/Bracket | ~7 nm † [74] | n.d. | 1.5 mg/mL (pre-coating) | N/A | N/A | N/A | N/A | [40] | 5 |
| 13 | b | ZnO/CQDs/Bracket | ~7 nm † [74] | n.d. | 1.5 mg/mL (pre-coating) | natural light | n.d. | n.d. | 24 h | [40] | 4d |
| 14 | a | LB hydrophobic CQDs thin film | 5 nm/~1 nm (height) | n.d. | n.d. | 470 nm | 15 W | 50 cm * | 0–6 h | [36] | 8 |
| 14 | b | “green carbon dots” (GCD) | 4–7 nm | n.d. | 0.01–1 mg/mL | dark conditions | N/A | N/A | 24 h | [22] | 6b |
© 2020 by the authors. Licensee MDPI, Basel, Switzerland. This article is an open access article distributed under the terms and conditions of the Creative Commons Attribution (CC BY) license (http://creativecommons.org/licenses/by/4.0/).
Share and Cite
Knoblauch, R.; Geddes, C.D. Carbon Nanodots in Photodynamic Antimicrobial Therapy: A Review. Materials 2020, 13, 4004. https://doi.org/10.3390/ma13184004
Knoblauch R, Geddes CD. Carbon Nanodots in Photodynamic Antimicrobial Therapy: A Review. Materials. 2020; 13(18):4004. https://doi.org/10.3390/ma13184004
Chicago/Turabian StyleKnoblauch, Rachael, and Chris D. Geddes. 2020. "Carbon Nanodots in Photodynamic Antimicrobial Therapy: A Review" Materials 13, no. 18: 4004. https://doi.org/10.3390/ma13184004
APA StyleKnoblauch, R., & Geddes, C. D. (2020). Carbon Nanodots in Photodynamic Antimicrobial Therapy: A Review. Materials, 13(18), 4004. https://doi.org/10.3390/ma13184004





